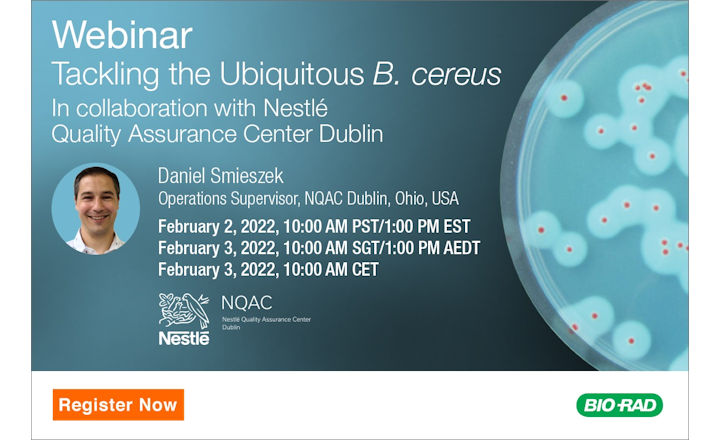
Webinar: Tackling the Ubiquitous <em>B. cereus</em>

Join Neogen® for a webinar focusing on Bacillus cereus Testing. Neogen is driving innovation in Bacillus cereus testing with the ISO-validated Neogen Petrifilm® Bacillus cereus Count Plate. This latest Petrifilm Count Plate offers food safety professionals a simple, reliable, and efficient method for the enumeration of Bacillus cereus, whilst overcoming challenges faced with the traditional testing method.
In this webinar, participants will learn:
- The latest scientific evidence regarding Bacillus cereus occurrence and challenges for food producers
- How the Petrifilm Bacillus cereus Count Plate enables comprehensive, accurate testing with fast, easy-to-interpret results
- How food laboratories can realise operational efficiencies with Petrifilm Count Plates through streamlined workflows and reduced environmental impact compared to traditional agar methods
- Insights into the ISO 16140-2 validation and performance data of the Petrifilm Bacillus cereus Count Plate
This webinar will be presented in English with closed caption translations available in French, German, Polish, Italian, and Spanish.